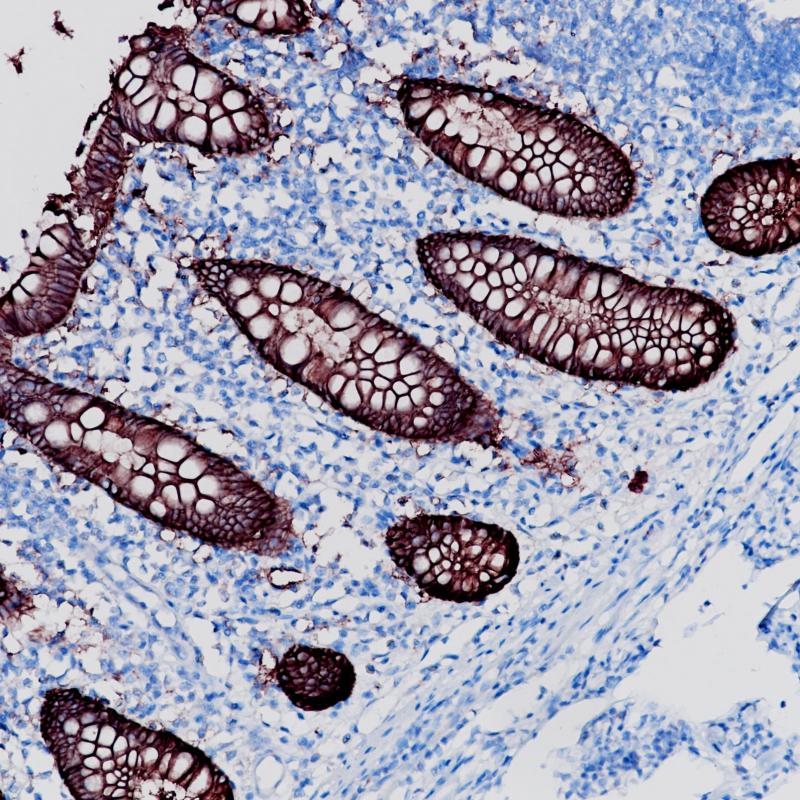

Colon

Appendix
EpCAM Recombinant Rabbit Monoclonal Antibody
Epithelial cell adhesion molecule (EpCAM) is a transmembrane glycoprotein, may act as a physical homophilic interaction molecule between intestinal epithelial cells (IECs) and intraepithelial lymphocytes (IELs) at the mucosal epithelium for providing immunological barrier as a first line of defense against mucosal infection. It plays a role in embryonic stem cells proliferation and differentiation, and it up-regulates the expression of FABP5, MYC and cyclins A and E.
This glycoprotein is located on the cell membrane surface (preferentially basolaterally) and in the cytoplasm of virtually all epithelial cells with the exception of most squamous epithelia, hepatocytes, renal proximal tubular cells, gastric parietal cells and myoepithelial cells. However, focal positivity may be seen in the basal layer of squamous cell epithelium of endoderm (e.g., palatine tonsils) and mesoderm (e.g., uterine cervix). Normal mesothelial cells are EpCAM negative, but may express focal reaction when undergoing reactive changes. EpCAM has been seen in the majority of epithelial neoplasms, whereas most non-epithelial neoplasms do not show EpCAM expression.
In conjunction with other markers, EpCAM can be used as an aid in determining neoplasms of epithelial origin, such as distinguishing between lung adenocarcinoma and mesothelioma.
This glycoprotein is located on the cell membrane surface (preferentially basolaterally) and in the cytoplasm of virtually all epithelial cells with the exception of most squamous epithelia, hepatocytes, renal proximal tubular cells, gastric parietal cells and myoepithelial cells. However, focal positivity may be seen in the basal layer of squamous cell epithelium of endoderm (e.g., palatine tonsils) and mesoderm (e.g., uterine cervix). Normal mesothelial cells are EpCAM negative, but may express focal reaction when undergoing reactive changes. EpCAM has been seen in the majority of epithelial neoplasms, whereas most non-epithelial neoplasms do not show EpCAM expression.
In conjunction with other markers, EpCAM can be used as an aid in determining neoplasms of epithelial origin, such as distinguishing between lung adenocarcinoma and mesothelioma.
Specifications
- Catalog No.
- BX50051
- Clone No.
- BP6056
- Application
- IHC-P
- Subcellular location
- Membrane
- Control
- Colon
- Recommended method
- HIER
- Volume
- 100μl/vial, 1ml/vial
- Dilution
- 1:100-1:200
- Immunogen
- Synthetic peptide corresponding to EpCAM residues within aa1-100 of EpCAM was used as an immunogen.
Reference
1.Latza et al. J Clin Pathol. 1990;43:213-19.
2.Ordonez NG et al. Am J Clin Pathol 1998;109(1):85-89.
Support Documents
Order
- E-mail : sales@biolynx.cn



